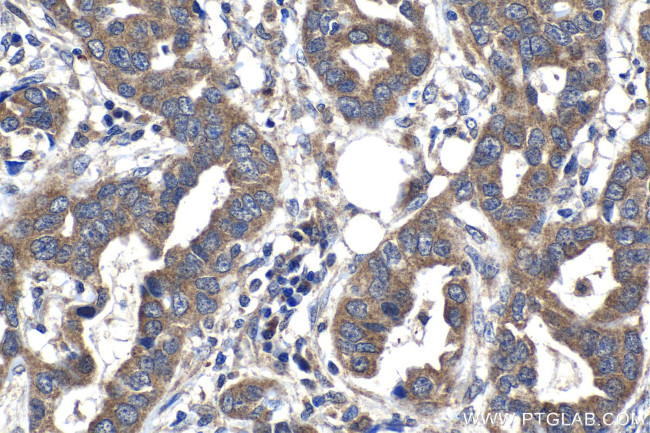
SPDYC Antibody in Immunohistochemistry (Paraffin) (IHC (P))

Search
Proteintech
SPDYC Polyclonal Antibody
{{$productOrderCtrl.translations['antibody.pdp.commerceCard.promotion.promotions']}}
{{$productOrderCtrl.translations['antibody.pdp.commerceCard.promotion.viewpromo']}}
{{$productOrderCtrl.translations['antibody.pdp.commerceCard.promotion.promocode']}}: {{promo.promoCode}} {{promo.promoTitle}} {{promo.promoDescription}}. {{$productOrderCtrl.translations['antibody.pdp.commerceCard.promotion.learnmore']}}
产品信息
22471-1-AP
种属反应
宿主/亚型
分类
类型
抗原
偶联物
形式
浓度
规格
纯化类型
保存液
内含物
保存条件
运输条件
产品详细信息
Immunogen sequence: MLWAIPELGS PCPISISYEM SDSQDPTTSP VVTTQVELGG CSRQGGGNGF LRFRQHQEVQ AFLSLLEDSF VQEFLSKDPC FQISDKYLLA MVLVYFQRAH LKLSEYTHSS LFLALYLAND MEEDLEGPKC EIFPWALGKD WCLRVGKFLH QRDKLWARMG FRAVVSRQCC EEVMAKEPFH WAWTRDRRPH HGGVQRVCPQ VPVRLPRGPG LSPPHCSPCG LPQHCSSHLL KPVSSKCPSL TSECHRPPSQ NYLSRVKNAW GGDFLIVLPP QMQLEPGTYS LRIFPKPPAR PGH
靶标信息
Promotes progression through the cell cycle via binding and activation of CDK1 and CDK2. Involved in the spindle-assembly checkpoint. Required for recruitment of MAD2L1, BUBR1 and BUB1 to kinetochores. Required for the correct localization of the active form of Aurora B in prometaphase.
仅用于科研。不用于诊断过程。未经明确授权不得转售。
篇参考文献 (0)
生物信息学
蛋白别名: hSpy/Ringo C; Rapid inducer of G2/M progression in oocytes C; RINGO C; speedy; speedy homolog C; Speedy protein C; speedy/ringo C
基因别名: Ringo2; RINGOC; SPDYC; SPDYE4
UniProt ID: (Human) Q5MJ68
Entrez Gene ID: (Human) 387778